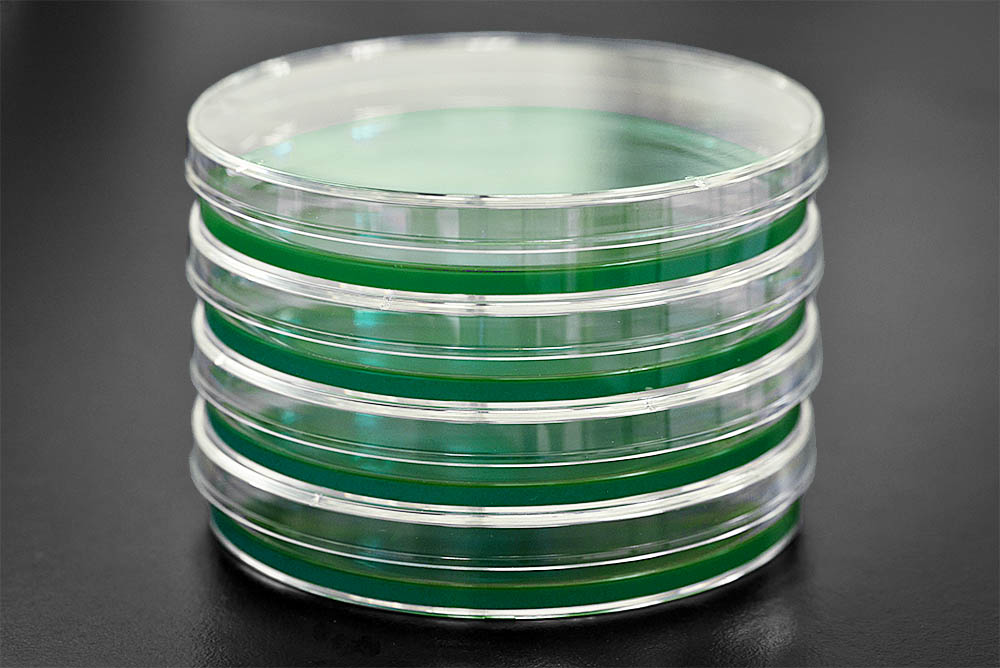
MEA Agar for Fungi Culturing – Sterile, High-Quality Malt Extract Agar
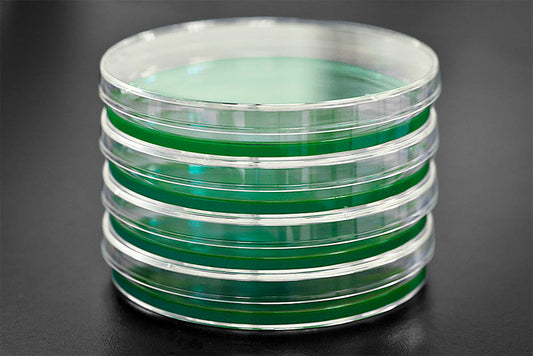
MEA Agar for Fungi Culturing – Sterile, High-Quality Malt Extract Agar

Hand Made
Secure Payment
Quick Shipping
Small Business
Highly Rated
Agar de extracto de malta Placas de Petri personalizadas
Descubra el medio de cultivo definitivo para sus cultivos microbianos con nuestras placas MEA (agar de extracto de malta). Elaborados con una mezcla de extracto de malta, azúcar y agar, estos platos brindan un entorno rico y rico en nutrientes para que sus cultivos prosperen. La adición de azúcar garantiza una fuente de carbono equilibrada, mientras que el extracto de malta proporciona vitaminas y minerales esenciales. Cada placa está esterilizada y lista para usar, lo que le facilita comenzar sus experimentos con confianza. Tanto si es estudiante, investigador o profesional, nuestras placas de agar MEA son la opción ideal para todas sus necesidades de microbiología. Experimente resultados consistentes y confiables con cada uso.
Su compra incluye :
- 10 placas de Petri MEA prevertidas
- Retractilado en juegos de 5 o 10
- No incluye Parafilm
Ingredientes:
- Polvo de agar de grado de laboratorio
- Extracto de malta extra ligero
- Azúcar en bruto
- Agua destilada
*Los colores variarán dependiendo del inventario actual*